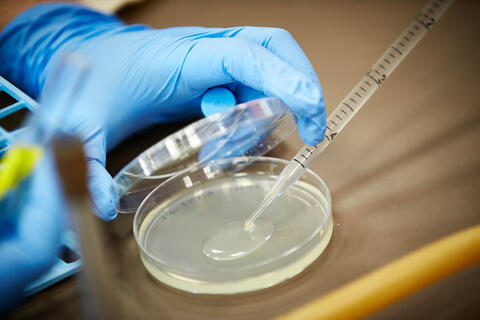

News: Graduate College
MGM College Opportunity Program at UNLV offers a flexible and affordable way for the company's employees to complete their degrees.
College of Sciences Alumnus of the Year Travis Huxman: Being a Rebel means having the courage to take a seat at any table.

School of Public Health Alumna of the Year Tracy Donnelly, noted for her work on a study about lead levels in candy, is currently helping Canada's indigenous population get access to higher education.

These faculty members aren't just accomplished in their academic fields. They all have one thing in common: success in the hobbies they're passionate about.

UNLV’s reintroduction effort keeps leopard frog species off the endangered list.

UNLV researchers monitored the motion of the thoracic spine, lumbar spine, and knee as part of the testing process.

Graduate College Alumna of the Year Constance Brooks has served public policy in stints with Clark County, NSHE, and MGM Resorts.

Tiffany Tyler-Garner works to fight dropout rate among students, foster training and rehabilitation for Nevada employees.

School of Integrated Health Sciences Alumna of the Year Anne Lindsay focuses on nutrition, obesity, and eating disorders among women and children.

Through a new KUNV podcast, Latinx students are at the helm of creating historical content in an accessible format.

She is inspired by the goals, values, and dreams of her students at the Academic Success Center.

UNLV sociologist on how interacting in online white supremacist networks can convert hateful words into real violence.
